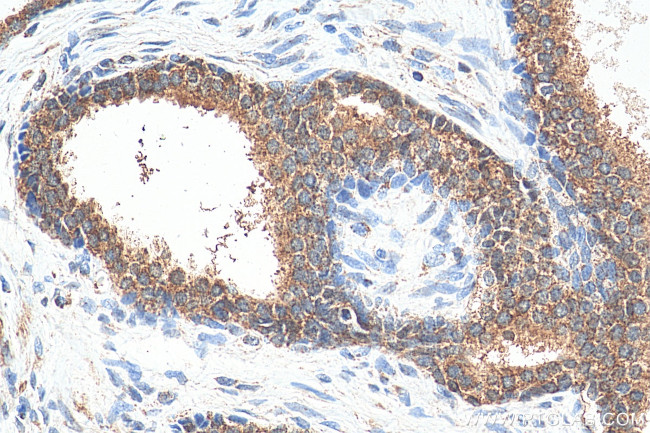
PLK1 Antibody in Immunohistochemistry (Paraffin) (IHC (P))

Search
Proteintech
PLK1 Polyclonal Antibody
{{$productOrderCtrl.translations['antibody.pdp.commerceCard.promotion.promotions']}}
{{$productOrderCtrl.translations['antibody.pdp.commerceCard.promotion.viewpromo']}}
{{$productOrderCtrl.translations['antibody.pdp.commerceCard.promotion.promocode']}}: {{promo.promoCode}} {{promo.promoTitle}} {{promo.promoDescription}}. {{$productOrderCtrl.translations['antibody.pdp.commerceCard.promotion.learnmore']}}
产品信息
10305-1-AP
种属反应
已发表种属
宿主/亚型
分类
类型
抗原
偶联物
形式
浓度
规格
纯化类型
保存液
内含物
保存条件
运输条件
产品详细信息
Immunogen sequence: VDYSDKYGL GYQLCDNSVG VLFNDSTRLI LYNDGDSLQY IERDGTESYL TVSSHPNSLM KKITLLKYFR NYMSEHLLKA GANITPREGD ELARLPYLRT WFRTRSAIIL HLSNGSVQIN FFQDHTKLIL CPLMAAVTYI DEKRDFRTYR LSLLEEYGCC KELASRLRYA RTMVDKLLSS RSASNRLKAS (415-603 aa encoded by BC002369)
靶标信息
PLK1 is a serine/threonine kinase that is thought to function in cell mitosis and regarded as a marker of cell proliferation. It has been found to play a critical role in carcinogenesis. Polo-like kinase proteins acts by binding and phosphorylating proteins are that already phosphorylated on a specific motif recognized by the POLO box domains. Phosphorylates BORA, BUB1B/BUBR1, CCNB1, CDC25C, CEP55, ECT2, ERCC6L, FBXO5/EMI1, FOXM1, KIF20A/MKLP2, CENPU, NEDD1, NINL, NPM1, NUDC, PKMYT1/MYT1, KIZ, PPP1R12A/MYPT1, PRC1, RACGAP1/CYK4, SGOL1, STAG2/SA2, TEX14, TOPORS, p73/TP73, TPT1 and WEE1. Plays a key role in centrosome functions and the assembly of bipolar spindles by phosphorylating KIZ, NEDD1 and NINL.
仅用于科研。不用于诊断过程。未经明确授权不得转售。
生物信息学
蛋白别名: cell cycle regulated protein kinase; PLK 1; PLK-1; polo (Drosophia)-like kinase; polo-like kinase; Polo-like kinase 1; polo-like kinase homolog; Serine/threonine-protein kinase 13; Serine/threonine-protein kinase PLK1; STPK13; STPK14; unnamed protein product
基因别名: PLK; PLK1; STPK13
UniProt ID: (Human) P53350, (Mouse) Q07832, (Rat) Q62673
Entrez Gene ID: (Human) 5347, (Mouse) 18817, (Rat) 25515